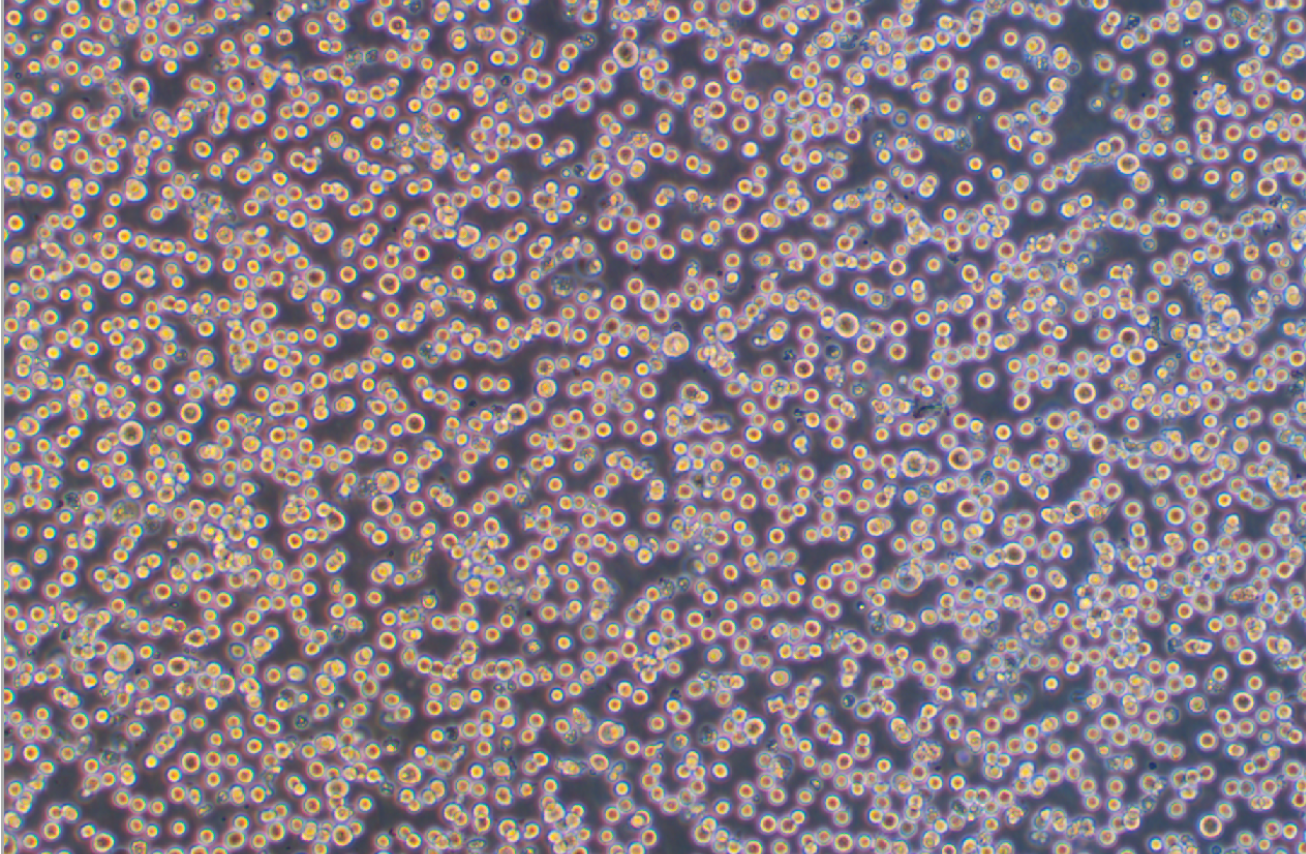
人成巨核細胞白血病細胞MEG-01(STR鑒定正確)

|
種屬 |
人 |
|
別稱 |
Meg-01; MEG01; Meg01 |
|
組織來源 |
骨; 骨髓 |
|
疾病 |
慢性粒細胞白血病 |
|
傳代比例/細胞消化 |
1:2傳代 |
|
完全培養(yǎng)基配置 |
RPMI1640培養(yǎng)基;10%胎牛血清;1%雙抗 |
|
簡介 |
MEG-01細胞株源自一位CML患者成巨核細胞轉(zhuǎn)換期的骨髓細胞。細胞質(zhì)因子VIII和表面球蛋白IIb/IIIa,高碘酸-Schiff(PAS)反應(yīng),α醋酸萘酯酶和酸性磷酸酶陽性。髓過氧化物酶,α丁酸萘酯酶,氯化醋酸AS-D萘苯酚酯酶和堿性磷酸酶陰性。用單克隆抗體BA-1(抗B細胞,粒性白細胞),HPL-3(抗球蛋白IIb/IIIa)和20.3(抗單核細胞,血小板)染色成陽性。其他淋巴和骨髓類抗體成陰性 |
|
形態(tài) |
淋巴母細胞樣 |
|
生長特征 |
懸浮生長 |
|
倍增時間 |
每周 2 至 3 次 |
|
STR |
Amelogenin: X,Y CSF1PO: 10 D13S317: 8 D16S539: 9 D5S818: 13 D7S820: 11 THO1: 7 TPOX: 8,11 vWA: 16 |
|
培養(yǎng)條件 |
氣相:空氣,95%;二氧化碳,5%。 溫度:37攝氏度,培養(yǎng)箱濕度為70%-80%。 |
|
凍存條件 |
凍存液:90%FBS,DMSO 10%, 或使用非程序凍存液:官網(wǎng)貨號JY-H040 |
|
保藏機構(gòu) |
ATCC; CRL-2021 |
|
備注 |
該細胞為懸浮細胞,請注意離心收集細胞懸液,請勿直接倒掉細胞培養(yǎng)液 |
|
產(chǎn)品使用 |
僅限于科學(xué)研究,不可作為動物或人類疾病的治療產(chǎn)品使用。 |